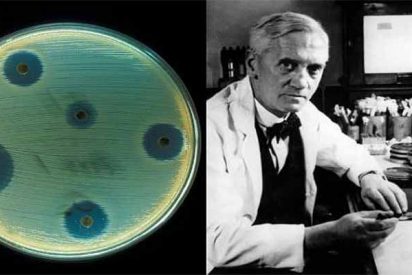
Hasta el 80% de los al&eacute;rgicos a la penicilina deja de serlo a los 10 a&ntilde;os

ARCOmadrid: El arte peruano conquista Madrid
ARCOmadrid es una de las Ferias Internacionales de arte contemporaneo más importantes de Europa. Este año reunirá a un total de 203 galerías de 30 países, de las cuales 165 integran el Programa General, sumándose a ellas las secciones comisariadas: "Perú en ARCO", con una selección de artistas de diferente galerías. Contacto Travellers
La indepe Pilar Rahola presume de haber visto en ruso ‘El acorazado Potemkin’… que es una película muda
¡Virgen Santa qué tropa! (La paja mental de una lanzada Pilar Rahola tras excitarse con el "éxito" de la mortífera vía eslovena ). La verdad es que produce cierta melancolía observar la evolución de Pilar Rahola, que a diferencia de casi todos sus compinches actuales es una persona viajada, leída y con idiomas (La machista de Pilar Rahola ataca
Cinco razones para visitar la Riviera Maya en pareja
Si estás planeando un viaje con tu pareja a la Riviera Maya, es la mejor elección que puedas. Este destino paradisíaco tiene mil y una razones para que tu estancia sea inolvidable. Aquí te reseñamos cinco. Contacto Travellers @monzonpaul Ver esta publicación en Instagram What will be your next adventure in the #RivieraMaya? Jumping from the zipline in Xcaret
Esta mirada del Rey de España a Torra después de la chulería del presidente catalán lo dice todo
La mala educación de estos independentistas llega a tal extremo que convierten un momento importante para la economía española, como lo es el Mobile World Congress, en una escena de patio de colegio entre el bajito y gordito acomplejado frente al alto y atlético. (Espectacular chorreo de Marhuenda y Jamardo al independentista defensor del "fracasado y don nadie Torra").
Miriam Sánchez, ex de Pipi Estrada, detenida cuando robaba en unos grandes almacenes
Miriam Sánchez, quien fuera flamante ganadora de 'Supervivientes' y consejera del amor de 'Mujeres y Hombres y Viceversa' junto a quien entonces era su pareja, Pipi Estrada, ha sido pillada en El Corte Inglés del Paseo de la Castellana en Madrid cuando se apropiaba de artículos y productos valorados en 900 euros aproximadamente, según publica en exclusiva Cotilleo.es
Hallan ahorcado Brody Stevens, el actor de ‘Resacón en Las Vegas’
La culpa, como casi siempre, la han tenido las depresión (El despreciable vídeo con insultos a su amigo muerto en el accidente de Tenerife: "Que le den"). El cómico Steven Brody Stevens, conocido en España por su papel en la primera y segunda parte de la saga de Resacón en Las Vegas y Salidos de cuentas, ha sido hallado muerto en su casa de Los Ángeles. Thank
Amazonías Perú en ARCOMadrid 2019
Matadero Madrid acoge, en el marco de la programación de Perú como país invitado de ARCOMadrid 2019, la exposición colectiva Amazonías, que reúne un centenar de propuestas de 46 autores peruanos y latinoamericanos provenientes de la colección del MALI, una de las más amplias y representativas de toda Latinoamérica, y de otras importantes
EL PSOE utiliza la TV de Aragón para intentar frenar a VOX
Mónica Naranjo y el sexo: «Probé la viagra femenina y me puse como una burra»
Seguimos sin entender qué le aporta a la artista este tipo de programa a su carrera,, pero ella sigue manifetsando su alegría. 'Mónica y el sexo': el nuevo programa de sexo de Mónica Naranjo en Mediaset Hace unos días, Mediaset hacía oficial la compra del nuevo programa de Mónica Naranjo, ‘Mónica y el sexo', una noticia adelantada en exclusiva
El negocio de las plazas de garaje en Madrid Central aumenta con precios desorbitados
La entrada en vigor de Madrid Central el área de prioridad residencial que restringe el tráfico privado en el centro, ha puesto en marcha ya el negocio de las plazas de garaje, cuyo precio de venta ha aumentado significativamente en la zona. Los precios de venta aumentan cada mes que pasa. De hecho, el distrito Centro ya es el que tiene las plazas de aparcamiento más caras de la
¿Viste la alocada actuación de «El Cejas» con la que ha conseguido el pase de oro de «Got Talent»?
El programa sigue sorprendiendo gracias a sus concursantes, aunque se trate de tonterías como esta. Telecinco llevaba varios días anunciando que el «Got Talent» de este lunes iba a ser especial. El talent show de Mediaset está todavía en la primera fase del concurso, en la que los aspirantes desfilan antes los jueces (Risto Mejide, Edurne, Paz Padilla y Eva Isanta),
José Pablo López convierte a Telemadrid en ‘La Sextilla’: audiencias en picado, purgas ideológicas y mucho dinero para Roures
Se cumplen dos años desde aquel 22 de febrero de 2017 en el que José Pablo López Sánchez, con la bendición de Cristina Cifuentes e Ignacio Aguado, tomó posesión de su cargo como director general de Telemadrid. Proveniente de 13TV, López Sánchez presumió de venir a despolitizar Telemadrid. Anunció su pretensión de acabar
Kepa Arrizabalaga se rebela en el Chelsea y se niega a ser sustituido
No es habitual ver algo así en un partido de fúbol. El "motín del Chelsea" pasará a la historia como una de las imágenes más surrealistas que se han visto sobre un campo de fútbol, según recoge BBC News Mundo. Y sucedió en los minutos finales de la prórroga de la final de la Copa de la Liga de Inglaterra que terminó ganando
El bestial corte de Casado a Franganillo (TVE) cuando le invita a un debate electoral en La1
Lluvia de críticas a «Boom» por lo que ha pasado con ‘Los Lobos’: «Vaya tongazo»
Las redes están muy pendientes de lo que sucede en su concurso favorito.Los espectadores de Boom (Antena 3) han criticado al programa este lunes por lo que ha ocurrido con Los Lobos y su equipo rival, Mastodontes, en una prueba de desempate. Algunos han empleado el término "amaño" y "tongo" para referirse a lo que Juanra Bonet, presentador del concurso, ha hecho, según huffingtonpost.
El bestial chine que se cogió Wyoming con el insulto de ‘El Bigotes’
Álvaro Pérez 'El Bigotes', en la cárcel por la trama Gürtel, nos da grandes momentos habitualmente cuando declara desde la prisión, pero este 25 de febrero de 2019 dio un paso más allá: Mi hijo muchas veces me pregunta que por qué me sacan tanto en este programa cuando llevas dos años en la cárcel y estás callado. Mire, quería
¿Quieres ver cómo está ahora Conchita Wurst?
Lo que sea por llamar la atención. Lejos ha quedado el melenón al que nos tenía acostumbrados Conchita Wurst, la artista que se hizo con la victoria de Eurovisión 2014, según huffingtonpost. Wurst, muy amiga de los cambios de look, ha desvelado en su cuenta de Instagram su nuevo peinado: rapada al cero. Así acudió a la gala para conmemorar los 30 años
El vídeo con el que Jorge Ramos hizo estallar de ira al dictador Nicolás Maduro
El jocoso comentario de Ana Rosa sobre la campaña electoral que revoluciona el plató y a sus tertulianos
Ana Rosa Quintana arrancó muy fuerte su programa en Telecinco este 26 de febrero de 2019, con un comentario jocoso, inesperado y nada habitual para la presentadora: Bienvenidos todos, ahora vamos a vivir hasta que sean las elecciones de anuncio en anuncio, de campaña en campaña, de a ver quien la tiene... Los compañeros tertulianos trataron de sacar a la presentadora del
Rahola entra en una paranoia mental con tal de justificar que un mamarracho que cobra de la TV3 llamase puta a Arrimadas
El polémico alcalde de Alcorcón será el número dos de Isabel Díaz Ayuso
La candidatura del PP de Madrid a la Presidencia de la Comunidad de Madrid, que lidera Isabel Díaz Ayuso, ha decidido que el alcalde de Alcorcón, David Pérez, sea su número dos. "Con esta decisión se pretende aprovechar la experiencia de gestión y la eficacia de las políticas que ha desarrollado David Pérez al frente de uno de los principales
Neymar al borde de las lágrimas al hablar de Messi
Una de las estrellas del Paris Saint-Germain (PSG), el brasileño Neymar Jr., no ha podido ocultar las lágrimas al recordar los agradables momentos que vivió en las filas del F.C. Barcelona junto a figuras como el argentino Lionel Messi, según rt. En un adelanto de una entrevista concedida al programa 'Esporte Espetacular' de Globo Tv, que se emitirá el próximo
Así justifica Rahola que el mamarracho que llamó puta a Arrimadas siga en TV3: «Tampoco deberían estar en TV Inda y Espada»
Así justifica la radical Rahola que el mamarracho que llamó puta a Inés Arrimadas siga colaborando en la pública catalana TV3:--La indepe Pilar Rahola presume de haber visto en ruso 'El acorazado Potemkin'... que es una película muda-- "Tampoco deberían estar en TV Inda y Espada, las privadas también reciben dinero público" La ultra Pilar Rahola tuvo que comerse el marrón de defender que TV3
Los impresionantes movimientos al estilo ninja del brasileño ‘Demoledor’ dejan atónitos a los fanáticos de las MMA
Este sábado, el luchador brasileño Michel Pereira cautivó una vez más al mundo de las artes marciales mixtas con su despliegue de acrobáticos movimientos ante el surcoreano Dae Sung Kim durante la velada Road FC 52, celebrada en Seúl (Corea del Sur), según rt. Pereira de 25 años, llevó la pelea a otro nivel y consiguió noquear a
Se viraliza este mensaje dedicado a Messi escrito por un jugador del Sevilla tras caer derrotado ante el Barcelona
El jugador del Sevilla Fútbol Club Wissam Ben Yedder utilizó su cuenta de Twitter para elogiar el trabajo de Lionel Messi después del gran desempeño del argentino en el partido de Liga que enfrentó este sábado al F.C. Barcelona y al club andaluz en el estadio Ramón Sánchez Pizjuán, según rt. Ben Yedder hizo notar su admiración
El jocoso comentario de Ana Rosa sobre la campaña electoral que revoluciona el plató y a sus tertulianos
La moda del BLACK DETOX o cómo los alimentos negros influyen en nuestro cuerpo
Alejandro Cánovas, dietista y nutricionista nos desvela los secretos del carbón activado, ese componente que tiñe los alimentos de negro y los hace antioxidantes (a parte de más cool)... ¿Cuántos años nos habremos propuesto lo mismo? Cuidarnos, comer sano, hacer más deporte... Cada vez nos entran antes las prisas por empezar. Para ello buscamos cualquier remedio que nos ayude a liberarnos de
Hasta el 80% de los alérgicos a la penicilina deja de serlo a los 10 años
Nueve de cada diez personas que creen que son alérgicas a la penicilina o no son alérgicas o solo tienen algo de intolerancia, y ocho de las diez personas que tuvieron una reacción alérgica en algún momento a la penicilina hace 10 o más años ya no son alérgicos, según los doctores Derek Chu y David McCullagh, de la Universidad McMaster
Qué ver en Brasil: Natal
Natal es la capital del estado de Rio Grande del Norte, al Noreste del país. Su nombre significa Navidad ya que fue fundada el día de Navidad de 1599 por los portugueses. Contacto Travellers @monzonpaul Ver esta publicación en Instagram Nosso RN está cheio de paisagens lindas! Pense num estado que Deus caprichou ??? Quem aí concorda? ???♂️ ⠀⠀⠀⠀⠀⠀⠀⠀⠀
La exposición a compuestos perfluorados pueden reducir el crecimiento fetal
La exposición a compuestos perfluorados pueden reducir el crecimiento fetal, según ha evidenciado un estudio llevado a cabo por investigadores de la Universidad de Aarhus (Dinamarca) y que ha sido publicado en el 'Environmental Health Perspectives'. "Las sustancias perfluoradas pueden imitar a la hormona estrógeno y, por lo tanto, pueden alterar los procesos hormonales naturales del cuerpo, incluido
Clima: Las emisiones de CO2 están disminuyendo en economías desarrolladas
Los esfuerzos por reducir las emisiones de dióxido de carbono (CO2) y hacer frente al cambio climático en las economías desarrolladas están comenzando a dar sus frutos. Según una investigación dirigida por el Centro Tyndall en la Universidad de East Anglia (UEA), las políticas que apoyan la energía renovable y la eficiencia energética están
Un ‘laboratorio en chip’ que detecta el cáncer más rápido y de manera menos invasiva
Un nuevo dispositivo de diagnóstico ultrasensible inventado por investigadores de la Universidad de Kansas, el Centro de Cáncer de la Universidad de Kansas y el Centro Médico KU en EEUU, podría permitir a los médicos detectar el cáncer rápidamente de una gota de sangre o plasma, lo que llevaría a intervenciones más rápidas, baratas
Vuelos baratos a Fortaleza, Brasil
Fortaleza es la ciudad más grande de todo el noreste brasileño, además de ser la capital del estado de Ceará. Contacto Travellers @monzonpaul La ciudad cuenta con infraestructuras de primer orden. El aeropuerto internacional de Pinto Martins - Fortaleza es sin duda el más importante de esta región del país, con un importante tráfico de pasajeros.
Investigadores descubren una nueva enfermedad esquelética rara
Investigadores del Instituto Karolinska (Suecia) han descubierto una nueva enfermedad esquelética rara, que encaja dentro del grupo de displasias esqueléticas. En un estudio publicado en la revista 'Nature Medicine', describen el mecanismo molecular de esta patología, en el que las pequeñas moléculas de ARN desempeñan un papel que nunca antes se había observado en una enfermedad humana congénita.
El increible caso del Grupo Municipal Popular menguante de Medina del Campo
Nubarrones negros se ciernen sobre el Grupo Municipal Popular en el Ayuntamiento de Medina del Campo. Parece ser que en próximas fechas, muy próximas, varios concejales, cuatro o cinco según distintas informaciones, pasarán al grupo mixto, abandonando así el Partido Popular. La marcha de los concejales, todavía no está claro el número exacto de
Lydia Lozano pide perdón a José Frade por sus metida de pata tras la muerte de Adriana Rothlander
El pasado viernes, una triste y emocionada Lydia Lozano era la encargada de abrir el programa Sálvame para rendirle homenaje a su amiga Adriana Rothlander que había fallecido ese mismo día a primera hora de la mañana. Entre lágrimas, además de lamentarse por la fatal noticia de la que era una de sus grandes amigas, la colaboradora del programa de Telecinco
Telemadrid, en complicidad con el golpismo: colaboradores del programa de María Rey piden «no darle importancia» a la prepotencia de Torra con el Rey
Otra muestra de chulería de Quim Torra hacia la jefatura de Estado y una televisión pública madrileña, Telemadrid, donde algunos colaboradores entienden que "no hay que darle importancia". Este es el panorama que pulula un día más por la que debería ser la tele de todos los madrileños y muchos españoles. El programa presentado por Maria
El récord de aceleración de plasma, batido en un tubo de 20 centímetros
Utilizando un láser para perforar a través de un plasma, científicos del Lawrence Berkeley National Laboratory (LBNL) han establecido un nuevo récord mundial para los aceleradores de plasma. En un tubo de plasma de solo 20 centímetros de largo, los científicos aceleraron los electrones a una energía de 7.800 millones de electronvoltios (GeV), un valor
Ana Rosa Quintana se harta en directo: noquea a Irene Montero y ridiculiza a Podemos
Caliente la mañana (La discusión de Ana Rosa Quintana en directo: "Discúlpeme, pero es la primera vez que yo le hablo"). La portavoz(a) de Podemos, Irene Montero, acudía este martes 26 de febrero al Programa de Ana Rosa con la firme intención de iniciar su particular campaña electoral y en ese papel prácticamente no dejaba hablar al resto de la mesa
Una aguja inteligente capaz de administrar medicamentos de forma precisa e indolora
Investigadores de Brigham and Women's Hospital (Estados Unidos) han desarrollado una aguja inteligente altamente sensible que permite administrar medicamentos de manera adecuada y segura en pruebas preclínicas. Un lugar al que es difícil apuntar con una aguja estándar es el espacio supracoroideo (SCS), el cual se encuentra entre la esclerótica y la coroides en la parte posterior
Los nuevos tratamientos antivirales permiten el trasplante de corazón de pacientes con hepatitis C
Investigadores de la Facultad de Medicina de la Universidad de Pennsylvania (Estados Unidos) han curado a nueve pacientes del virus de la hepatitis C (VHC) después de haberles realizado un trasplante de corazón de donantes que murieron infectados por la enfermedad. De esta forma, han demostrado que este trasplante desde donantes infectados no es perjudicial para los infectados siempre
Identifican un gen que puede predecir el cáncer de páncreas en diabetes tipo 2
Investigadores de la Clínica Mayo (Estados Unidos) han identificado un gen llamado UCP-1 que puede predecir el desarrollo de cáncer de páncreas en personas con diabetes tipo 2. Sus conclusiones se publican en la revista 'Gastroenterology'. En el estudio, los científicos estudiaron una cohorte poblacional de pacientes con cáncer de páncreas y controles emparejados.
Máxima tensión: la guardia bolivariana ocupa un puente fronterizo con Colombia
La tensión está desbocada en Venezuela y alrededores, no es ninguna novedad, pero sorprende mucho cada vez que se ve algún movimiento militar como éste de la Policía Nacional Bolivariana de la Venezuela de Maduro, tratando de ocupar un puente fronterizo con la Colombia que de pronto se ha vuelto enemiga de los chavistas por reconocer como legítimo presidente
Las estrellas viejas, como los rockeros, tardan en morir más de lo que se pensaba
Las gigantes rojas, invisibles para el ojo humano, eran, oficialmente y hasta el momento, los objetos que mayor pérdida de masa sufrían. Pero, en realidad,resisten más de lo pensado. Pero las estructuras espirales detectadas por un equipo internacional formado por investigadores de 14 instituciones científicas europeas --entre las que se encuentra el Instituto de Astrofísica
El Rey saca a Irene Montero fuera de sí y la podemita la emprende contra Ana Rosa hasta que la presentadora estalla
La negativa a ir al besamanos del Rey por parte de Ada Colau encendió la mecha en el plató de Ana Rosa Quitana con la invitada Irene Montero este 26 de febrero de 2019. Algo nada nuevo porque no es el primer año que sucede: la alcaldesa de Barcelona le da la mano al Rey cuando le saluda, pero no cuando hay un acto protocolario que se llama besamanos, aunque nadie le bese la mano
Cardenal George Pell, el mayor jerarca de la Iglesia católica en ser condenado por abuso sexual
Duele en lo más profundo (Las víctimas, divididas ante el discurso del Papa en la clausura de la cumbre antipederastia). Era considerado como un asesor cercano al Papa, quien lo convocó en 2014 a Roma para ayudar a poner orden en las finanzas de la iglesia. Como tesorero de la Santa Sede, George Pell era visto como el tercer hombre más poderoso del Vaticano. Ahora se ha
El ‘Pequeño’ Nicolás y su imaginativa estrategia para llegar a las elecciones
El pequeño Nicolas ya no es tan pequeño (El atrevido vídeo electoral del 'pequeño Nicolás': "¿Quieres vivir como hace diez años?"). El ex concursante de Gran Hermano VIP nos ha sorprendido a todos con la creación de un partido político. Siempre hemos sabido que lo suyo era la política, de hecho recordemos que su salto a la fama fue
María Lapiedra con el culo al aire: se ha inventado toda su historia, ¡qué sorpresa!
María Lapiedra ha roto con su novio, Gustavo González, y ha vuelto a primera línea informativa de la prensa rosa. Pero puede que sea todo una farsa y el 25 de febrero de 2019, en ‘Sálvame' se dieron pruebas de ello. El miércoles 20 de febrero de 2019, María Lapiedra y Gustavo González vendieron su ruptura amorosa en sendas exclusivas. Ella alegaba
Así explica en 20 segundos Jordi Cuixart lo que ocurrió con los coches de la Guardia Civil
Cuixart niega el carácter violento del «procés» y califica a la sociedad catalana como «pacífica» en cualquier situación. «Cuando estaba vivo el dictador nos defendíamos de la misma manera», asegura, sobre lo que él considera el ejercicio de derechos fundamentales. Admite y lamenta los daños a los coches de la Guardia
Ana Rosa Quintana e Irene Montero bregando en el plató
Máxima tensión: la guardia bolivariana ocupa un puente fronterizo con Colombia
Análisis político de un cabo del ejército de cara a las elecciones
Análisis político de un cabo del ejército de cara a las elecciones. Muchos son los compañeros que nos preguntan por redes sociales ¿ahora qué?, refiriéndose a la intención de voto en las próximas elecciones en lo que al problema de la temporalidad de Tropa y Marinería se refiere. No seré yo el que le diga a nadie a quien votar,
Así explica en 20 segundos Jordi Cuixart lo que ocurrió con los coches de la Guardia Civil
Salvador Monzó Romero: «Ahora»
Más que plumas un pájaro y un pez escamas,Ha de tener quien en Política vuele o nade;Hoy quien en esta afición se ande por las ramasO se salga del charco, mejor se hace cofradeEn una Procesión, o resuelve crucigramas;En ella a muchos les salen los huevos sin yema,O sin jugo las huevas, por no saberse el tema;Medran los más listos y los mejores talentosCeden
Miguel Cancio: » Sobre la Misa por el alma de nuestro muy querido amigo Jose Luis Mari Solera “Licho», Proyectos Lichianos o Licheiros y Hölderlin»
Los "Amigos de Licho" informamos que la Misa por nuestro muy querido amigo José Luís Mari Solera "Licho", gran ferrolano-compostelano, gallego, español y ciudadano del mundo, medico, doctor, catedrático, músico, poeta, artista, gran dinamizador espiritual, cultural y social de Santiago de Compostela, y gran defensor de España, la gran nación española
¿Sabías que la carne vegana de laboratorio no es mejor para el cambio climático que la de verdad?
Es uno de los temas más comentados en el mundo de la salud y la dietética. Hemos hablado largo y tendido del enorme impacto ambiental de nuestro consumo de carne. Según estimaciones de la FAO, el ganado es causante de un 65 % de las emisiones de gases de efecto invernadero producidas por la actividad humana, un impacto que no dejará de subir a medida que la dieta de las
Manuel del Rosal García: «La hortera presentación del libro de Pedro Sánchez»
La presentación del libro de Pedro Sánchez recuerda los momentos televisivos de plebiscito para alimentar la vanidad insaciable de esos dictadorzuelos de las repúblicas bananeras. Raro es el día en que no nos llega una de esas horteradas desde Venezuela. La presentación del libro de Pedro Sánchez en TVE ha sido una horterada tal y como esta palabra está
Victor Entrialgo De Castro: «Mentiras, ilusiones y desengaños»
La vida privada es la que importa. La pública interesa sobre todo en cuanto puede estropearnos la privada. Ahora que vamos a sufrir por culpa del presidente por accidente ¡cinco insoportables meses! de una artificiosidad tediosa, asoman los primeros postureos obscenamente mentirosos de los acusados y sus colaboradores necesarios, todavía por acusar, los okupas poschalets y el okupa
La NASA confirma que la luna Titán podría albergar una «extraña vida alienígena basada en metano»
La NASA considera la posibilidad de que la luna Titán de Saturno, que alberga mares y precipitación de hidrocarburos, podría albergar una "extraña vida alienígena basada en metano". La científica planetaria Amanda Hendrix, co-líder del nuevo programa de exploración de mundos océanicos de la NASA (Roadmaps to Oceans World Group) subraya
El fantasma de Pablo Escobar en la implosión del edificio Mónaco
El 22 de febrero de 2019 fue derribado el edificio Mónaco, la última residencia de Pablo Escobar y su familia, y símbolo del narcotráfico. Minutos antes de la implosión, testigo grabaron la aparición de un supuesto fantasma que, dicen en redes sociales, se podría tratar del cabecilla del Cartel de Medellín. Con 375 kilos de explosivos y en 3,2 segundos cayó la estructura blanca de ocho pisos,
Muchas risas con la campaña del PP contra los bailones Sánchez, Iglesias y Maduro al ‘ritmo de la noche’
Este luchador de la UFC gana combate con un golpe tan fuerte que el protector bucal de su rival salió volando
Los luchadores del peso wélter Dwight Grant y Carlo Pedersoli Jr. se enfrentaron el pasado sábado en las preliminares del evento deportivo UFC Fight Night 145, en Praga, República Checa, según rt. Cerca del final del último asalto, Grant ganó la pelea con un devastador gancho de derecha en la mandíbula de Pedersoli, que lo envió a la lona, donde
Las memorias del agente Mikel ‘El Lobo’ Lejarza: «Puigdemont y Oleguer Pujol estaban en el entorno de Terra Lliure»
La leyenda de Mikel Lejarza, El Lobo, se inicia en 1974 cuando se infiltra en ETA. Desde el interior de la organización terrorista, consiguió asestar el peor golpe de su historia criminal: la detención de más de 200 activistas. Han pasado 45 años desde entonces y, en contra de lo que la gran mayoría de la gente piensa, Lejarza ha seguido trabajando para el servicio de inteligencia español, la
Sobre la misa por José Luís Mari Solera «Licho», proyectos Lichianos o Licheiros, Hölderlin y la lucha por el bien
Los “Amigos de Licho” informamos que la Misa por nuestro muy querido amigo José Luís Mari Solera "Licho", gran ferrolano-compostelano, gallego, español y ciudadano del mundo (difundió su pensamiento, su arte, poesía, música, con su gaita y ocarina, no solo por Galicia y España, sino tambien por Europa y América del sur y el norte incluido Canadá), medico, doctor, catedrático, músico,
El hundimiento definitivo de Kiko Matamoros: Se descubre lo que su nueva novia le ha ocultado
¿Nos está volviendo a tomar el pelo Kiko Matamoros? Mientras le colaborador sigue vendiendo su nueva relación sentimental como el paraíso en la tierra, en ‘Sálvame' no le creen. Y para colmo, el 26 de febrero de 2019 , la revista Semana ha destapado los problemas legales (y ocultos) de Cristina Pujol, la novia de Kiko. Es todo un negocio. No decimos que Kiko
Losantos encuentra el nexo de unión de tantos independentistas: «A ver si lo son por alguna deficiencia estética porque mira que son feos los tíos»
Federico Jiménez Losantos ha encontrado la razón que une a tantos y tantos independentistas: "a ver si todos ellos lo son por una especie de deficencia estética".--Esta mirada del Rey de España a Torra después de la chulería del presidente catalán lo dice todo-- La estrella de esRadio ha comentado con sorna y guasa la falta de atractivo físico
Un pasajero graba cómo su avión se ladea de forma brusca en el aire debido a vientos extremos
Un pasajero de un Airbus A320 de British Airways que partió este lunes del aeropuerto de Londres-Heathrow con destino a Gibraltar grabó las dificultades para mantener el equilibrio que experimentó el avión mientras atravesaba unos vientos cruzados a baja altitud, según rt. La aeronave ya estaba cerca de la zona de aterrizaje cuando empezó a balancearse de forma brusca, y como consecuencia de
SEAT Minimó: «La movilidad urbana del mañana»
SEAT ha presentado en el Mobile World Congress 2019 el vehículo que asegura marcará la diferencia en la estrategia de micromovilidad urbana de la firma: Minimó, un concept car 100 % eléctrico y con capacidad para dos personas. En él se ha integrado un sistema de intercambio de baterías que permite la recarga completa del vehículo "en unos pocos minutos",
Encuentran a esta ballena en la selva brasileña muy lejos del mar
Una ballena jorobada o yubarta ha aparecido muerta en la selva, a 15 metros de la playa de Araruna, en el municipio de Soure, del estado brasileño de Pará, informa la prefectura en su cuenta de Facebook, según rt. Según especialistas de Bicho D'água, se trata de una cría de ocho metros de largo y seis de ancho de un año de edad. Su cuerpo, que no presentaba heridas visibles, será sometido a
SEAT Minimó: «La movilidad urbana del mañana»
Fuente: YT
Los 10 países más saludables del mundo ¿Estará España entre ellos?
Este año España ha desbancado a Italia como el país más sano del mundo. Así lo atestigua el nuevo Índice de País más Saludable elaborado por Bloomberg, que estudia 169 economías del mundo. En esta entrega, el país íbero ha dado un salto desde la sexta posición, que ocupaba en 2018, hasta liderar el 'ranking'. Entre
Estupor en Telecinco por la confirmación ‘oficial’ de que Teresa Campos está arruinada
Estos días los pasillos de Telecinco arden con una noticia que se comenta entre bastidores y que pasa de boca en boca no sin asombro de todo el que escucha una historia que puede describir perfectamente el ocaso de quien fuera toda una estrella televisiva (¿Cómo es posible que Terelu Campos se colara en los Oscar comiendo una porra?). Según aseguran a Periodista Digital
Expulsan de la escuela a niños huérfanos por miedo a que contagien el VIH a sus compañeros
En Indonesia, 14 niños huérfanos de entre primero y cuarto año de primaria fueron expulsados de su escuela en la ciudad de Surakarta por tener el virus del VIH, que contrajeron de sus madres al nacer. Según las autoridades educativas de la ciudad, el instituto no tuvo otra opción, ya que la información sobre los 14 niños se hizo pública y todos
Descubren que el Gobierno argentino realiza ‘spots’ visitando siempre «por sorpresa» a la misma mujer pobre
Este domingo la gobernadora de la provincia argentina de Buenos Aires, María Eugenia Vidal (que responde al presidente Mauricio Macri), subió en distintos formatos a sus redes sociales la visita que realizó a una mujer humilde del municipio de Escobar. El encuentro se intentó mostrar como una "sopresa" de parte de la funcionaria. Allí la anfitriona, en su casa de
Continua el ‘via crucis’ para Toño Sanchis con una nueva demanda de otra representada
Hay un refrán que dice que "al perro flaco todo se le vuelven pulgas", y parece que Toño Sanchis se ha convertido el 'Pulgoso', el famosos perro de dibujos animados Las malas noticias no cesan para el ex representante de Belén Esteban. Tras verse obligado a marcharse de su chalé por la deuda contraída, y no pagada, con la de San Blas, ahora el manager artístico
Descubren que el Gobierno realiza ‘spots’ visitando siempre «por sorpresa» a la misma mujer pobre
Fuente: YT
Agente inmobiliario salta de acantilado para ganarse la confianza de unos clientes
Un agente inmobiliario llamado Jock Kooger saltó en traje y corbata desde un acantilado en Manly (Auckland, Nueva Zelanda) para convencer a dos de sus clientes -dueños de una casa de lujo valorada en 1,5 millones de dólares- de que haría lo que fuera para vender su vivienda, según se aprecia en un video grabado por la dueña de la casa y publicado este domingo
Agente inmobiliario salta de acantilado para ganarse la confianza de unos clientes
Un agente inmobiliario llamado Jock Kooger saltó en traje y corbata desde un acantilado en Manly (Auckland, Nueva Zelanda) para convencer a dos de sus clientes -dueños de una casa de lujo valorada en 1,5 millones de dólares- de que haría lo que fuera para vender su vivienda, según se aprecia en un video grabado por la dueña de la casa y publicado este domingo
Así eres en la CAMA según tu signo del zodiaco
Los signos del zodiaco dicen mucho de nosotros, de nuestra personalidad, nuestras aficiones e incluso cómo somos en la cama o con nuestra pareja. Según el horóscopo los afortunados con el signo de Acuario son los que mejor sexo tienen y Virgo tienen las parejas más sexuales. En la cama, a los Tauro son los que más les gusta jugar en la cama con juguetes sexuales, o al menos los que más compran
¡Adiós, tecnología! Los GADGETS faciales de moda vienen de la China imperial
En la era de la digitalización vivimos también una interesante corriente que mira hacia el pasado, que recupera artes y medios pre-tecnológicos, y que apuesta por detenerse un instante para avanzar de una manera más humana. Podríamos hablar de su influencia en gastronomía o moda, pero en el caso de la belleza resulta muy visible su irrupción, a través de filosofías orientales y terapias alternativas
Disney estrena nuevo tráiler de ‘EL REY LEÓN’ y ya no podemos esperar más para ver la peli
Disney ha querido aprovechar la gran noche de los Premios Oscar para anunciar lo que se viene. Por eso ha sacado a la luz un nuevo adelanto de la esperada película El rey león, esa que no hemos podido evitar emocionarnos cuando supimos que iban a hacer un remake. 25 años después del estreno de la película original, Disney se ha atrevido con un live action, es
Venezolano humilla a cuatro mexicanos que defienden a Maduro
Los lloriqueos indepedentistas de Talegón en Cuatro es lo último que le faltaba a la tele cutre de Vasile
Peatones levantan un coche para salvar a una niña de dos años que fue atropellada
En la ciudad de Zhangzhou al este de China, una niña de dos años fue atropellada y quedó atrapada bajo la rueda trasera del auto. Tras el percance, varios peatones se acercaron rápidamente para levantar el vehículo y rescatar a la menor, informó este jueves CCTV, según rt. La pequeña caminaba a pocos metros de su madre en las inmediaciones de
Belén Esteban se mete en un lío tremendo al desvelar un secreto que une a Toño Sanchís con un jefazo de Telecinco
Nueva batalla entre Belén Esteban y Toño Sanchís. Después del ‘Deluxe' en el que ella volvía a explicar cómo le ganó el juicio a su exprepresentante, el 26 de febrero de 2019, la de Paracuellos ha confesado algo incendiario que afecta a un alto cargo de Telecinco. ¿Hablamos de Vasile? Primero, Kiko Matamoros dijo en ‘Sálvame'
Carme Forcadell, ante el Supremo, no es tan valiente como cuando era presidenta del Parlament
Más Celia Villalobos que nunca: tremenda regañina a Carme Chaparro con varios golpes al mentón
Espectacular Celia Villalobos en 'Al Día' de Cuatro este 26 de febrero de 2019, para disgusto de Carme Chaparro, la presentadora, que se llevó tal repaso de la política que se le habrán quitado las ganas de volver a entrevistarla. Celia Villalobos se rebota con Griso cuando le pone todas sus barrabasadas políticas en un vídeo El chorreo fue de aúpa y
El presidente de Turkmenistán se “flipa” así conduciendo a todo gas
El presidente de Turkmenistán, Gurbangulí Berdymujamédov, visitó la semana pasada el centro de deportes de motor del Ministerio del Interior del país, donde probó un nuevo modelo de deportivo, un Nissan 370Z, en un campo de 'drifting' con un área total de 4,35 hectáreas, según rt. Según la Agencia Estatal de Noticias de Turkmenistán,
El presidente de Turkmenistán se “flipa” así conduciendo a todo gas
Fuente:YT
¿Sabías que entre los vestidazos de las after party de los Oscar, se coló esta actriz en chándal?
En realidad no es nada original, aunque ha conseguido su propósito. Siempre se ha dicho y sigue siendo verdad. La alfombra roja de los Oscar es un escaparate de moda en el que podemos vislumbrar cuáles van a ser las tendencias del año. Las principales firmas se disputan a la gente del cine para que lleven sus diseños y de ahí que toda la fiesta aparezca siempre envuelta
Celia Villalobos metiéndole a Carme Chaparro
Mónica Hoyos se ‘cuela’ en la fiesta que ofreció Elton John tras los Oscar
¡Sin palabras! no hemos quedado en la redacción al ver las imágenes que ha subido Mónica Hoyos a su cuenta de Instagram. Ver esta publicación en Instagram Ahora os subo todo lo de ayer, thanks ? @ejaf #ejafoscars @eltonjohn ???? Una publicación compartida de Monica Hoyos (@monicahoyoss) el 25 Feb, 2019 a las 10:50 PST La ex concursante de ‘GH VIP
La soviética televisión pública de la socialista Rosa María Mateo veta a ‘VOX’
RTVE ha ofrecido un ‘debate a cuatro' el día 22 abril a las 22:00, en el que debatirán Pablo Casado (PP), Pedro Sánchez (PSOE), Pablo Iglesias (Podemos) y Albert Rivera (Ciudadanos), ningunenando de esta forma a VOX, el partido de Santiago Abascal, que si está invitado, con buen y democrático criterio, al debate de Atresmedia ('El Lechero' Fortes y sus amigos
Si te preocupa la caída del PELO… esto es lo que debes comer
El factor estético es algo que preocupa a muchas personas, tanto el aspecto del cuerpo, como la cara o el pelo. Y es que cuidar el pelo es algo esencial para mantenerlo bonito y evitar su caída. El pelo no nos cae solo de manera estacional y son muchos los factores que pueden afectar principalmente sobre esta zona. Desde factores externos como la contaminación o el clima, hasta factores internos
Así ven Alaska y Mario la nueva colección de DAVIDELFIN
Ayer se presentaba la colección Otoño-Invierno 2019-2020 de Davidelfin. La exposición de la nueva colección se podrá ver durante cinco días en el espacio Ekseption, en la calle Velázquez. El suelo del evento estaba forrado con lienzos que pisaban los invitados, para utilizarlos posteriormente a modo de decoración en las paredes, un acto muy Delfín
Lo que piensa Rocío Monasterio del feminismo lo compartirán muchas mujeres… [La Contra TV]
Para Monasterio el feminismo no es ilusionante. Rocío Monasterio nació en Cuba en 1974, pero pronto se trasladó a nuestro país junto a su familia. En España es donde ha pasado la mayor parte de su vida. Un vídeo de su intervención en HispanTV criticando a Fidel Castro y haciendo referencia a su propia infancia se hizo viral
Qué ver y hacer en Teneriife
Después de que Loro Parque se convirtiera en pionero, al ser el suyo el primer acuario de España en recibir a una pareja de tiburones ‘Rhina ancylostoma', la especie será trasladada en los próximos días a exhibición para que todos los visitantes puedan conocerla y aprender de ella. Contacto Travellers @monzonpaul Ver esta publicación en
La Justicia para en seco la jugada de Sánchez para sacar la momia de Franco del Valle de los Caídos
La primera en la frente y la segunda en el pecho (Los Franco 1 - Sánchez 0: no habrá exhumación de la momia antes de las elecciones generales). El Juzgado de lo Contencioso-Administrativo número 3 de Madrid ha suspendido de forma provisional el informe del Ayuntamiento de San Lorenzo de El Escorial, que concedía la licencia urbanística para llevar a cabo la
Loro Parque, reconocido como el zoológico número uno del mundo
Loro Parque ha vuelto a ser reconocido, por segundo año consecutivo, como MEJOR ZOOLÓGICO DEL MUNDO según el prestigioso portal de viajes TripAdvisor, que le ha otorgado el premio ‘Travellers' Choice 2018'. Un año más, las evaluaciones independientes de los usuarios de la plataforma que han visitado las instalaciones han confirmado que no hay otro parque mejor
El Gobierno Sánchez bloquea la subvención al Valle de los Caídos y en la red se organiza un ‘crowdfunding’ para ayudar a los monjes
Es una maniobra que huele a chantaje ( La Justicia para en seco la jugada de Sánchez para sacar la momia de Franco del Valle de los Caídos). Patrimonio Nacional, a instancias de Pedro Sánchez que no sabe como salir del embrollo, ha pedido a la Abadía del Valle de los Caídos que presente un "presupuesto equilibrado, fundamentado y veraz" para recibir 340.000 euros,